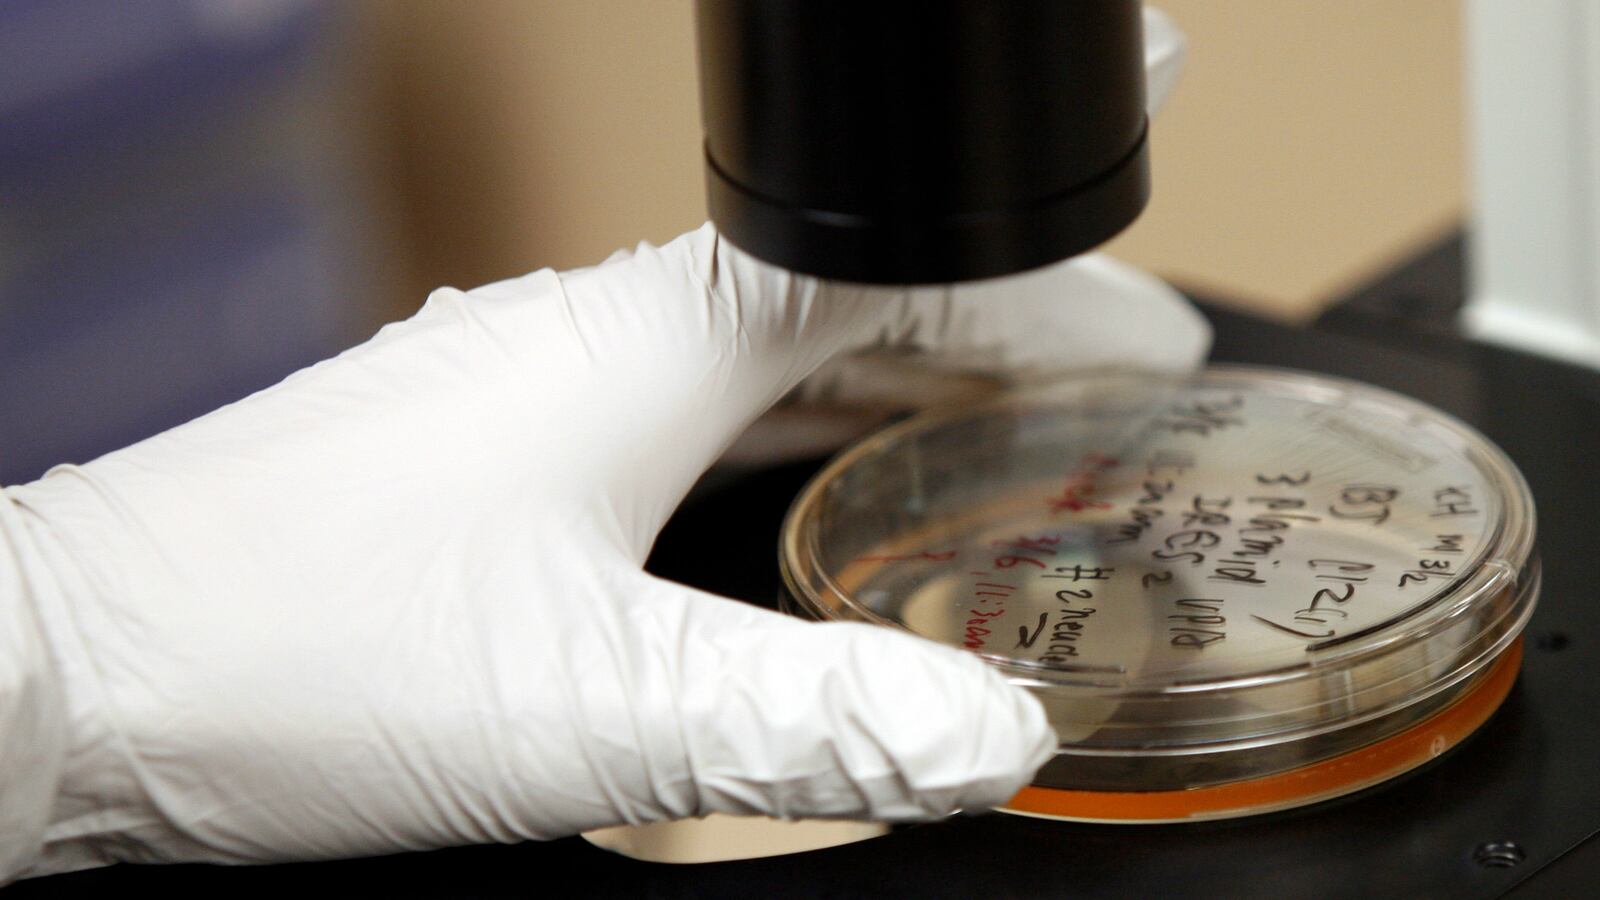
gonorrhea-superbug_xdep9c

In at least three known cases, strains of a gonorrhea “superbug” have developed a resistance to all antibiotics, the World Health Organization reports. The U.N. health agency estimates 78 million people per year contract the sexually transmitted disease, and it’s “only a matter of time” before last-resort antibiotics will be of no use globally. “Gonorrhea is a very smart bug,” said Teodora Wi, a specialist at the WHO. “Every time you introduce a new type of antibiotic to treat it, this bug develops resistance to it.” In many cases, the infection has no symptoms of its own but can lead to ectopic pregnancy, infertility, pelvic inflammatory disease, and an increased risk of contracting HIV. The three cases where no known antibiotics were effective were discovered in Japan, France, and Spain.
Read it at The Guardian